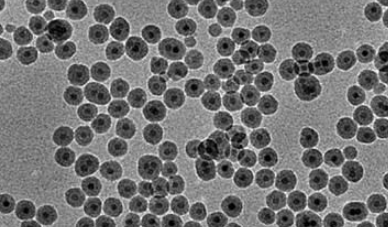
1701928620891631.png 图片55.png

四氧化三铁-GP-ICG(25nm),科研Iron trioxide GP-ICG (25nm)
产品名称:四氧化三铁-GP-ICG(25nm),科研Iron trioxide GP-ICG (25nm)
中文名称:四氧化三铁-GP-ICG(25nm)
英文名称:Iron trioxide GP-ICG (25nm)
粒径nm:10、20、30、40、50、60、70、80、100
形状:棒状、球形、立方形、核壳形等
分类:四氧化三铁化合物
外观:固体或粉末
颜色:黑色
CAS:/
规格:mg
纯度:95%+
溶解性:溶于部分有机溶剂
储存:/
用途:科研
品牌:西安齐岳生物科技有限公司
四氧化三铁-GP-ICG(25nm)是一种荧光修饰纳米粒复合物,具有良好的生物相容性和稳定性,可以在常温下保存且不易氧化。这种复合物是由四氧化三铁纳米粒子和GP-ICG荧光染料组成的,其中四氧化三铁纳米粒子作为载体,可以**地包裹和保护GP-ICG荧光染料,使其在血液循环中保持稳定。
推荐产品:
二金刚烷
1-Adamantyl Fluoride
1,1'-Bi(adamantane)
1-Methyladamantane
1-Phenyladamantane
1-金刚烷基乙酸
1-Adamantanemethylamine
多硝基金刚烷
N-亚水杨醛基-1-氨基金刚烷
1,3,5,7-四硝基金刚烷
2-硫代金刚烷
1,3,5,7-adamantane tetracarboxylate
西安齐岳生物可以提供四氧化三铁及四氧化三铁复合物的基础和定制(不同形貌 不同组合,含、载药) 等四氧化三铁系列产品。包括四氧化三铁纳米粒(油溶/水溶),PEG修饰的四氧化三铁,PLL修饰的四氧化三铁,PEI修饰四氧化三铁,PLGA修饰四氧化三,BSA修饰四氧化三铁,二氧化硅包裹四氧化三铁,棒状四氧化三铁,其他各种形貌四氧化三铁等基础与定制产品。
西安齐岳生物产品仅用于科研,不可用于人体,RL2023.12




 齐岳微信公众号
齐岳微信公众号
 官方微信
官方微信
 库存查询
库存查询